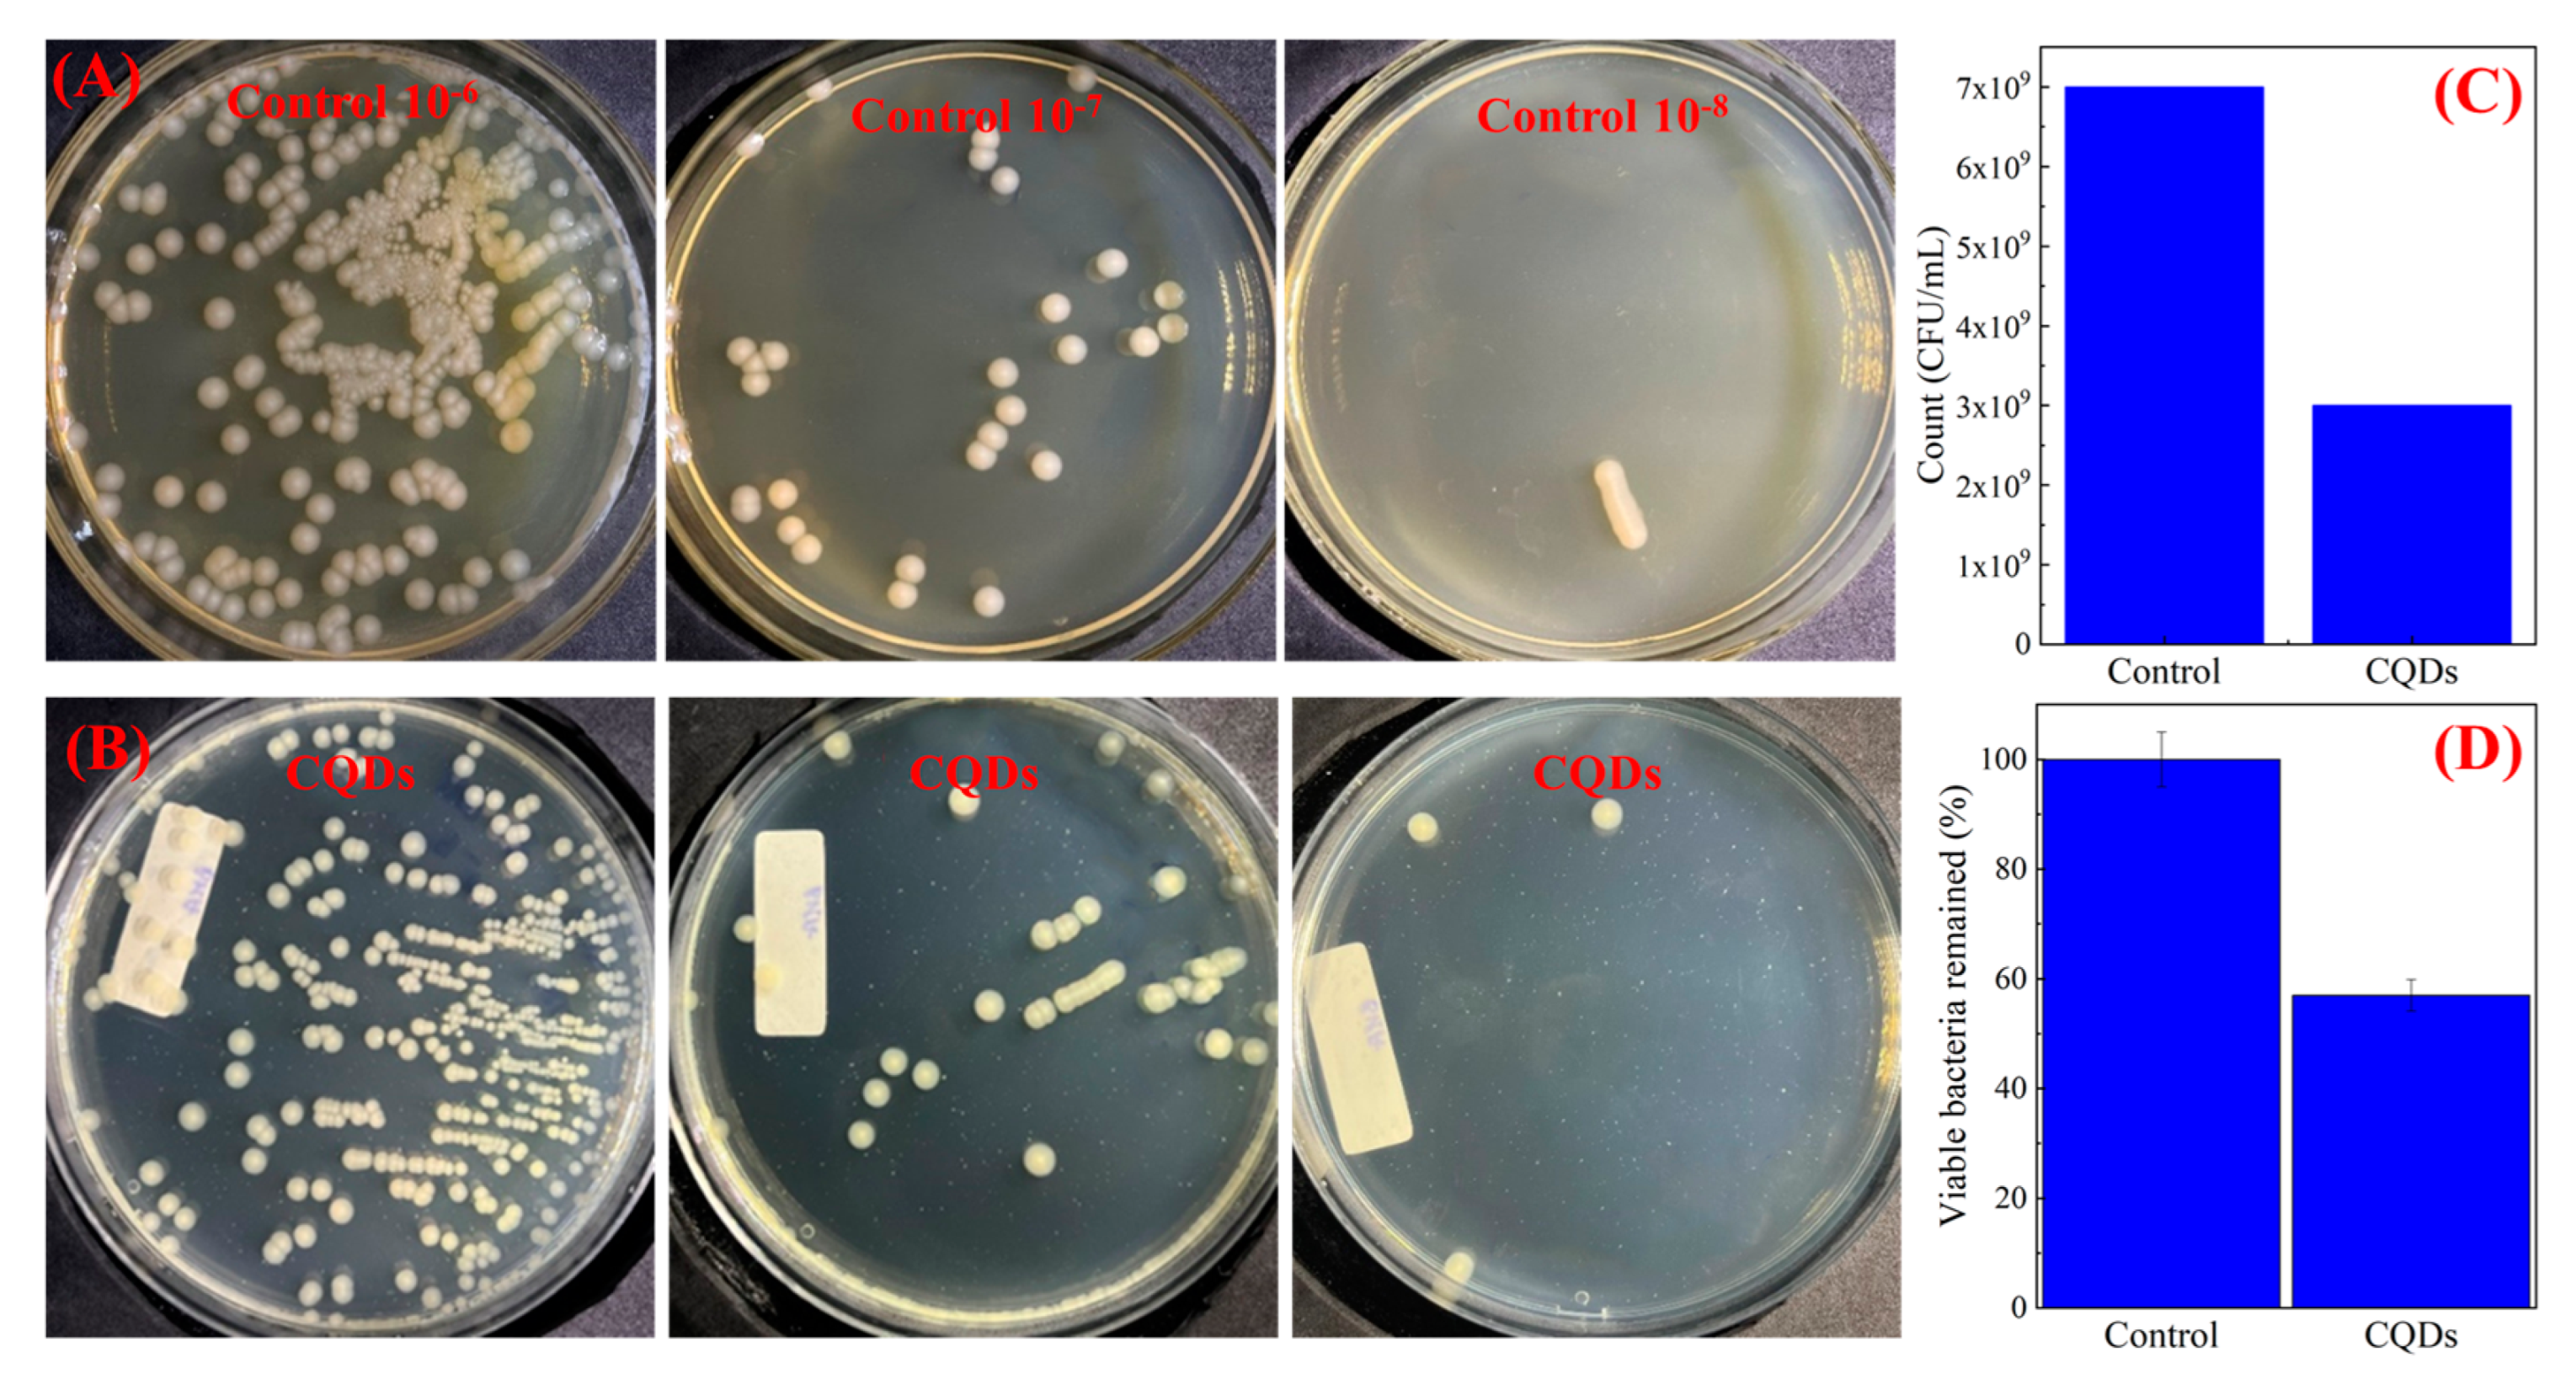
Applsci 14 02509 g006

A Comprehensive Study on the Antibacterial Activities of Carbon Quantum Dots Derived from Orange Juice against Escherichia coli
Abstract
1. Introduction
2. Materials and Methods
2.1. Synthesis of CQDs
2.2. Characterization
2.3. Antibacterial Activity Assay
3. Results
3.1. Structural Characterisation
3.2. Optical Properties
3.3. Antibacterial Properties
4. Conclusions
Author Contributions
Funding
Institutional Review Board Statement
Informed Consent Statement
Data Availability Statement
Acknowledgments
Conflicts of Interest
References
- Gagic, M.; Kociova, S.; Smerkova, K.; Michalkova, H.; Setka, M.; Svec, P.; Pribyl, J.; Masilko, J.; Balkova, R.; Heger, Z.; et al. One-Pot Synthesis of Natural Amine-Modified Biocompatible Carbon Quantum Dots with Antibacterial Activity. J. Colloid Interface Sci. 2020, 580, 30–48. [Google Scholar] [CrossRef]
- Schröfel, A.; Kratošová, G.; Šafařík, I.; Šafaříková, M.; Raška, I.; Shor, L.M. Applications of Biosynthesized Metallic Nanoparticles—A Review. Acta Biomater. 2014, 10, 4023–4042. [Google Scholar] [CrossRef] [PubMed]
- Lewinski, N.; Colvin, V.; Drezek, R. Cytotoxicity of Nanoparticles. Small 2008, 4, 26–49. [Google Scholar] [CrossRef]
- Huang, Y.W.; Cambre, M.; Lee, H.J. The Toxicity of Nanoparticles Depends on Multiple Molecular and Physicochemical Mechanisms. Int. J. Mol. Sci. 2017, 18, 2702. [Google Scholar] [CrossRef] [PubMed]
- Shen, L.M.; Liu, J. New Development in Carbon Quantum Dots Technical Applications. Talanta 2016, 156–157, 245–256. [Google Scholar] [CrossRef]
- Ren, W.; Chen, S.; Li, S.; Zhang, Y.; Liu, J.; Guan, M.; Yang, H.; Li, N.; Han, C.; Li, T.; et al. Photoluminescence Enhancement of Carbon Dots by Surfactants at Room Temperature. Chem. A Eur. J. 2018, 24, 15806–15811. [Google Scholar] [CrossRef]
- Baker, S.N.; Baker, G.A. Luminescent Carbon Nanodots: Emergent Nanolights. Angew. Chemie Int. Ed. 2010, 49, 6726–6744. [Google Scholar] [CrossRef]
- Parvathy, C.R.; Praseetha, P.K. Evaluation of Anti-Diabetic Potential of Anti-Microbial Carbon Quantum Dots from Vitis Vinifera Seeds. Nano Biomed. Eng. 2023, 15, 28–35. [Google Scholar] [CrossRef]
- Wu, Y.; Li, C.; van der Mei, H.C.; Busscher, H.J.; Ren, Y. Carbon Quantum Dots Derived from Different Carbon Sources for Antibacterial Applications. Antibiotics 2021, 10, 623. [Google Scholar] [CrossRef]
- Yang, J.; Zhang, X.; Ma, Y.H.; Gao, G.; Chen, X.; Jia, H.R.; Li, Y.H.; Chen, Z.; Wu, F.G. Carbon Dot-Based Platform for Simultaneous Bacterial Distinguishment and Antibacterial Applications. ACS Appl. Mater. Interfaces 2016, 8, 32170–32181. [Google Scholar] [CrossRef]
- Varisco, M.; Zufferey, D.; Ruggi, A.; Zhang, Y.; Erni, R.; Mamula, O. Synthesis of Hydrophilic and Hydrophobic Carbon Quantum Dots from Waste of Wine Fermentation. R. Soc. Open Sci. 2017, 4, 170900. [Google Scholar] [CrossRef]
- Guo, H.; Wen, S.; Li, W.; Li, M.; Wang, L.; Chang, Q.; Zhang, J.; Lai, J.; Vajtai, R.; Ajayan, P.M.; et al. A Universal Strategy to Separate Hydrophilic Hybrid-Light Carbon Quantum Dots Using Pure Water as Eluent. Appl. Mater. Today 2020, 18, 100528. [Google Scholar] [CrossRef]
- Kováčová, M.; Špitalská, E.; Špitálský, Z. Light-Activated Polymer Nanocomposites Doped with a New Type of Carbon Quantum Dots for Antibacterial Applications. In Urinary Stents: Current State and Future Perspectives; Springer International Publishing: Cham, Switzerland, 2022; pp. 315–324. [Google Scholar] [CrossRef]
- Mahat, N.A.; Nor, N.S.M.; Shamsudin, S.A. Effects of Positive Carbon Quantum Dots on Gram-Negative Bacteria as an Antimicrobial Agent. J. Inorg. Organomet. Polym. Mater. 2022, 32, 2428–2440. [Google Scholar] [CrossRef]
- Abu Rabe, D.I.; Al Awak, M.M.; Yang, F.; Okonjo, P.A.; Dong, X.; Teisl, L.R.; Wang, P.; Tang, Y.; Pan, N.; Sun, Y.P.; et al. The Dominant Role of Surface Functionalization in Carbon Dots’ Photo-Activated Antibacterial Activity. Int. J. Nanomed. 2019, 14, 2655–2665. [Google Scholar] [CrossRef]
- Selvaraju, N.; Ganesh, P.S.; Palrasu, V.; Venugopal, G.; Mariappan, V. Evaluation of Antimicrobial and Antibiofilm Activity of Citrus Medica Fruit Juice Based Carbon Dots against Pseudomonas Aeruginosa. ACS Omega 2022, 7, 36227–36234. [Google Scholar] [CrossRef]
- Sahu, S.; Behera, B.; Maiti, T.K.; Mohapatra, S. Simple One-Step Synthesis of Highly Luminescent Carbon Dots from Orange Juice: Application as Excellent Bio-Imaging Agents. Chem. Commun. 2012, 48, 8835–8837. [Google Scholar] [CrossRef] [PubMed]
- Surendran, P.; Lakshmanan, A.; Priya, S.S.; Balakrishnan, K.; Rameshkumar, P.; Kannan, K.; Geetha, P.; Hegde, T.A.; Vinitha, G. Bioinspired Fluorescence Carbon Quantum Dots Extracted from Natural Honey: Efficient Material for Photonic and Antibacterial Applications. Nano-Struct. Nano-Objects 2020, 24, 100589. [Google Scholar] [CrossRef]
- Chiang, W.H.; Mariotti, D.; Sankaran, R.M.; Eden, J.G.; Ostrikov, K. Microplasmas for Advanced Materials and Devices. Adv. Mater. 2020, 32, e1905508. [Google Scholar] [CrossRef] [PubMed]
- Lin, L.; Zhang, Z.; Min, Y. Microfluidic Plasma: Novel Process Intensification Strategy. Green Process. Synth. 2022, 11, 1064–1071. [Google Scholar] [CrossRef]
- Rathore, S.; Patel, D.K.; Thakur, M.K.; Haider, G.; Kalbac, M.; Kruskopf, M.; Liu, C.I.; Rigosi, A.F.; Elmquist, R.E.; Liang, C.T.; et al. Highly Sensitive Broadband Binary Photoresponse in Gateless Epitaxial Graphene on 4H–SiC. Carbon 2021, 184, 72–81. [Google Scholar] [CrossRef]
- Orriere, T.; Kurniawan, D.; Chang, Y.C.; Pai, D.Z.; Chiang, W.H. Effect of Plasma Polarity on the Synthesis of Graphene Quantum Dots by Atmospheric-Pressure Microplasmas. Nanotechnology 2020, 31, 485001. [Google Scholar] [CrossRef] [PubMed]
- Weerasinghe, J.; Scott, J.; Deshan, A.D.K.; Chen, D.; Singh, A.; Sen, S.; Sonar, P.; Vasilev, K.; Li, Q.; Ostrikov, K. Monochromatic Blue and Switchable Blue-Green Carbon Quantum Dots by Room-Temperature Air Plasma Processing. Adv. Mater. Technol. 2022, 7, 2100586. [Google Scholar] [CrossRef]
- Zheng, P.; Liu, R.; Wang, J.; Luo, Y.; Zhao, H.; Mao, X.; Lai, C. Cathode and Hollow Metal Anode with Miniature Argon Gas Flow. J. Appl. Spectrosc. 2022, 89, 141–149. [Google Scholar] [CrossRef]
- Yang, J.S.; Pai, D.Z.; Chiang, W.H. Microplasma-Enhanced Synthesis of Colloidal Graphene Quantum Dots at Ambient Conditions. Carbon 2019, 153, 315–319. [Google Scholar] [CrossRef]
- Breijyeh, Z.; Jubeh, B.; Karaman, R. Resistance of Gram-Negative Bacteria to Current Antibacterial Agents and Approaches to Resolve It. Molecules 2020, 25, 1340. [Google Scholar] [CrossRef] [PubMed]
- Dong, X.; Awak, M.A.; Tomlinson, N.; Tang, Y.; Sun, Y.P.; Yang, L. Antibacterial Effects of Carbon Dots in Combination with Other Antimicrobial Reagents. PLoS ONE 2017, 12, e0182324. [Google Scholar] [CrossRef] [PubMed]
- Fernando, K.A.S.; Sahu, S.; Liu, Y.; Lewis, W.K.; Guliants, E.A.; Jafariyan, A.; Wang, P.; Bunker, C.E.; Sun, Y.P. Carbon Quantum Dots and Applications in Photocatalytic Energy Conversion. ACS Appl. Mater. Interfaces 2015, 7, 8363–8376. [Google Scholar] [CrossRef] [PubMed]
- Dong, Y.; Pang, H.; Yang, H.B.; Guo, C.; Shao, J.; Chi, Y.; Li, C.M.; Yu, T. Carbon-Based Dots Co-doped with Nitrogen and Sulfur for High Quantum Yield and Excitation-Independent Emission. Angew. Chemie 2013, 125, 7954–7958. [Google Scholar] [CrossRef]
- Gu, J.; Zhang, X.; Pang, A.; Yang, J. Facile Synthesis and Photoluminescence Characteristics of Blue-Emitting Nitrogen-Doped Graphene Quantum Dots. Nanotechnology 2016, 27, 164704. [Google Scholar] [CrossRef]
- Zhu, S.; Zhang, J.; Tang, S.; Qiao, C.; Wang, L.; Wang, H.; Liu, X.; Li, B.; Li, Y.; Yu, W.; et al. Surface Chemistry Routes to Modulate the Photoluminescence of Graphene Quantum Dots: From Fluorescence Mechanism to up-Conversion Bioimaging Applications. Adv. Funct. Mater. 2012, 22, 4732–4740. [Google Scholar] [CrossRef]
- Jamaludin, N.; Tan, T.L.; Zaman, A.S.K.; Sadrolhosseini, A.R.; Rashid, S.A. Acid-Free Hydrothermal-Extraction and Molecular Structure of Carbon Quantum Dots Derived from Empty Fruit Bunch Biochar. Materials 2020, 13, 3356. [Google Scholar] [CrossRef]
- Qin, X.; Lu, W.; Asiri, A.M.; Al-Youbi, A.O.; Sun, X. Microwave-Assisted Rapid Green Synthesis of Photoluminescent Carbon Nanodots from Flour and Their Applications for Sensitive and Selective Detection of Mercury(II) Ions. Sens. Actuators B Chem. 2013, 184, 156–162. [Google Scholar] [CrossRef]
- Yadav, P.K.; Chandra, S.; Kumar, V.; Kumar, D.; Hasan, S.H. Carbon Quantum Dots: Synthesis, Structure, Properties, and Catalytic Applications for Organic Synthesis. Catalysts 2023, 13, 422. [Google Scholar] [CrossRef]
- Zhao, S.; Chen, X.; Zhang, C.; Zhao, P.; Ragauskas, A.J.; Song, X. Fluorescence Enhancement of Lignin-Based Carbon Quantum Dots by Concentration-Dependent and Electron-Donating Substituent Synergy and Their Cell Imaging Applications. ACS Appl. Mater. Interfaces 2021, 13, 61565–61577. [Google Scholar] [CrossRef] [PubMed]
- Zhao, S.; Lan, M.; Zhu, X.; Xue, H.; Ng, T.W.; Meng, X.; Lee, C.S.; Wang, P.; Zhang, W. Green Synthesis of Bifunctional Fluorescent Carbon Dots from Garlic for Cellular Imaging and Free Radical Scavenging. ACS Appl. Mater. Interfaces 2015, 7, 17054–17060. [Google Scholar] [CrossRef] [PubMed]
- Kelebek, H.; Selli, S. Determination of Volatile, Phenolic, Organic Acid and Sugar Components in a Turkish Cv. Dortyol (Citrus Sinensis L. Osbeck) Orange Juice. J. Sci. Food Agric. 2011, 91, 1855–1862. [Google Scholar] [CrossRef] [PubMed]
- Wang, C.S.; Chen, H.C.; Shih, W.C.; Cheng, H.F.; Lin, I.N. Effect of H2/Ar Plasma on Growth Behavior of Ultra-Nanocrystalline Diamond Films: The TEM Study. Diam. Relat. Mater. 2010, 19, 138–142. [Google Scholar] [CrossRef]
- Liu, M.L.; Chen, B.B.; Li, C.M.; Huang, C.Z. Carbon Dots: Synthesis, Formation Mechanism, Fluorescence Origin and Sensing Applications. Green Chem. 2019, 21, 449–471. [Google Scholar] [CrossRef]
- Lu, S.; Sui, L.; Liu, J.; Zhu, S.; Chen, A.; Jin, M.; Yang, B. Near-Infrared Photoluminescent Polymer–Carbon Nanodots with Two-Photon Fluorescence. Adv. Mater. 2017, 29, 1603443. [Google Scholar] [CrossRef]
- Long, P.; Feng, Y.; Li, Y.; Cao, C.; Li, S.; An, H.; Qin, C.; Han, J.; Feng, W. Solid-State Fluorescence of Fluorine-Modified Carbon Nanodots Aggregates Triggered by Poly(Ethylene Glycol). ACS Appl. Mater. Interfaces 2017, 9, 37981–37990. [Google Scholar] [CrossRef]
- Ftekan, A.K.; Alobaidi, Y.M.; Hamza, A.M. Antibacterial Activities of Carbon Quantum Dots Derived from Lemon Juice. AIP Conf. Proc. 2022, 2437, 020099. [Google Scholar] [CrossRef]
- Yadav, P.; Nishanthi, S.T.; Purohit, B.; Shanavas, A.; Kailasam, K. Metal Free Visible Light Photocatalytic Carbon Nitride Quantum Dots as Efficient Antibacterial Agents: An Insight Study. Carbon 2019, 152, 587–597. [Google Scholar] [CrossRef]
- Savaedi, S.; Soheyli, E.; Zheng, G.; Lou, Q.; Sahraei, R.; Shan, C. Excitation-Independent Deep-Blue Emitting Carbon Dots with 62% Emission Quantum Efficiency and Monoexponential Decay Profile for High-Resolution Fingerprint Identification. Nanotechnology 2022, 33, 445601. [Google Scholar] [CrossRef]
- Molaei, M.J. The Optical Properties and Solar Energy Conversion Applications of Carbon Quantum Dots: A Review. Sol. Energy 2020, 196, 549–566. [Google Scholar] [CrossRef]
- Chakravarty, A.; Ahmad, I.; Singh, P.; Ud Din Sheikh, M.; Aalam, G.; Sagadevan, S.; Ikram, S. Green Synthesis of Silver Nanoparticles Using Fruits Extracts of Syzygium Cumini and Their Bioactivity. Chem. Phys. Lett. 2022, 795, 139493. [Google Scholar] [CrossRef]
- Marković, Z.M.; Kováčová, M.; Humpolíček, P.; Budimir, M.D.; Vajďák, J.; Kubát, P.; Mičušík, M.; Švajdlenková, H.; Danko, M.; Capáková, Z.; et al. Antibacterial Photodynamic Activity of Carbon Quantum Dots/Polydimethylsiloxane Nanocomposites against Staphylococcus Aureus, Escherichia Coli and Klebsiella Pneumoniae. Photodiagnosis Photodyn. Ther. 2019, 26, 342–349. [Google Scholar] [CrossRef] [PubMed]
- Stanković, N.K.; Bodik, M.; Šiffalovič, P.; Kotlar, M.; Mičušik, M.; Špitalsky, Z.; Danko, M.; Milivojević, D.D.; Kleinova, A.; Kubat, P.; et al. Antibacterial and Antibiofouling Properties of Light Triggered Fluorescent Hydrophobic Carbon Quantum Dots Langmuir-Blodgett Thin Films. ACS Sustain. Chem. Eng. 2018, 6, 4154–4163. [Google Scholar] [CrossRef]
- Bhatt, S.; Bhatt, M.; Kumar, A.; Vyas, G.; Gajaria, T.; Paul, P. Green Route for Synthesis of Multifunctional Fluorescent Carbon Dots from Tulsi Leaves and Its Application as Cr(VI) Sensors, Bio-Imaging and Patterning Agents. Colloids Surf. B Biointerfaces 2018, 167, 126–133. [Google Scholar] [CrossRef] [PubMed]
- Shahshahanipour, M.; Rezaei, B.; Ensafi, A.A.; Etemadifar, Z. An Ancient Plant for the Synthesis of a Novel Carbon Dot and Its Applications as an Antibacterial Agent and Probe for Sensing of an Anti-Cancer Drug. Mater. Sci. Eng. C 2019, 98, 826–833. [Google Scholar] [CrossRef] [PubMed]
- Ashok Kumar, S.; Dheeraj Kumar, M.; Saikia, M.; Renuga Devi, N.; Subramania, A. A Review on Plant Derived Carbon Quantum Dots for Bio-Imaging. Mater. Adv. 2023, 4, 3951–3966. [Google Scholar] [CrossRef]

Disclaimer/Publisher’s Note: The statements, opinions and data contained in all publications are solely those of the individual author(s) and contributor(s) and not of MDPI and/or the editor(s). MDPI and/or the editor(s) disclaim responsibility for any injury to people or property resulting from any ideas, methods, instructions or products referred to in the content. |
© 2024 by the authors. Licensee MDPI, Basel, Switzerland. This article is an open access article distributed under the terms and conditions of the Creative Commons Attribution (CC BY) license (https://creativecommons.org/licenses/by/4.0/).
Share and Cite
Nguyen, M.H.; Le, A.T.; Pham, V.D.; Pham, H.M.; Do, H.T.; Le, D.T.; Vu, T.B.; Nguyen, T.B. A Comprehensive Study on the Antibacterial Activities of Carbon Quantum Dots Derived from Orange Juice against Escherichia coli. Appl. Sci. 2024, 14, 2509. https://doi.org/10.3390/app14062509
Nguyen MH, Le AT, Pham VD, Pham HM, Do HT, Le DT, Vu TB, Nguyen TB. A Comprehensive Study on the Antibacterial Activities of Carbon Quantum Dots Derived from Orange Juice against Escherichia coli. Applied Sciences. 2024; 14(6):2509. https://doi.org/10.3390/app14062509
Chicago/Turabian StyleNguyen, Minh Hoa, Anh Thi Le, Van Duong Pham, Hong Minh Pham, Hoang Tung Do, Duc Toan Le, Thi Bich Vu, and Thanh Binh Nguyen. 2024. "A Comprehensive Study on the Antibacterial Activities of Carbon Quantum Dots Derived from Orange Juice against Escherichia coli" Applied Sciences 14, no. 6: 2509. https://doi.org/10.3390/app14062509
APA StyleNguyen, M. H., Le, A. T., Pham, V. D., Pham, H. M., Do, H. T., Le, D. T., Vu, T. B., & Nguyen, T. B. (2024). A Comprehensive Study on the Antibacterial Activities of Carbon Quantum Dots Derived from Orange Juice against Escherichia coli. Applied Sciences, 14(6), 2509. https://doi.org/10.3390/app14062509






